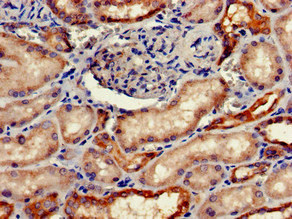
CSB-PA008651LA01HU

FGG
纖維蛋白原γ鏈(Fibrinogen Gamma Chain,F(xiàn)GG)是纖維蛋白原復(fù)合物的核心組分,與α、β鏈共同構(gòu)成血漿中重要的凝血蛋白,在UniProt中記錄為FGgamma或Fibrinogen gamma polypeptide。該蛋白在凝血級聯(lián)反應(yīng)中發(fā)揮關(guān)鍵作用,凝血酶將其切割后釋放纖維蛋白單體,通過交聯(lián)形成網(wǎng)狀結(jié)構(gòu),穩(wěn)定血栓并促進(jìn)傷口愈合。其異常表達(dá)或功能缺陷可能引發(fā)先天性纖維蛋白原缺乏癥,表現(xiàn)為出血傾向或異常血栓形成,部分突變還與遺傳性淀粉樣變性相關(guān)。臨床研究發(fā)現(xiàn),血漿FGG水平升高與動脈粥樣硬化、深靜脈血栓及腫瘤轉(zhuǎn)移風(fēng)險(xiǎn)顯著相關(guān),尤其在肝癌、胰腺癌中常作為預(yù)后標(biāo)志物。目前針對纖維蛋白原的藥物以抗凝劑為主,如直接凝血酶抑制劑比伐盧定,而針對FGG特異性的單克隆抗體尚處于臨床前研究階段。近年來,基于FGG結(jié)構(gòu)設(shè)計(jì)的靶向纖維蛋白溶解療法在溶栓藥物開發(fā)中受到關(guān)注,例如改良型組織纖溶酶原激活劑(tPA)的增效策略已進(jìn)入Ⅱ期臨床試驗(yàn)。
熱銷產(chǎn)品
Recombinant Human Fibrinogen gamma chain (FGG) (CSB-EP008651HU)
驗(yàn)證數(shù)據(jù)

(Tris-Glycine gel) Discontinuous SDS-PAGE (reduced) with 5% enrichment gel and 15% separation gel.
FGG Antibody (CSB-PA008651LA01HU)
驗(yàn)證數(shù)據(jù)
Immunohistochemistry of paraffin-embedded human kidney tissue using CSB-PA008651LA01HU at dilution of 1:100

Immunofluorescent analysis of Hela cells using CSB-PA008651LA01HU at dilution of 1:100 and Alexa Fluor 488-congugated AffiniPure Goat Anti-Rabbit IgG(H+L)

Western Blot
Positive WB detected in: Mouse heart tissue
All lanes: FGG antibody at 2.7μg/ml
Secondary
Goat polyclonal to rabbit IgG at 1/50000 dilution
Predicted band size: 52, 50 kDa
Observed band size: 52 kDa
Human Fibrinogen Gamma Chain (FGG)ELISA Kit (CSB-E13319h)
驗(yàn)證數(shù)據(jù)

貨號:CSB-E13319h
規(guī)格:96T/48T
靈敏度:31.25 ng/mL
檢測范圍:125 ng/mL-8000 ng/mL
These standard curves are provided for demonstration only. A standard curve should be generated for each set of samples assayed.
FGG Antibodies
FGG for Homo sapiens (Human)
| 產(chǎn)品貨號 | 產(chǎn)品名稱 | 種屬反應(yīng)性 | 應(yīng)用類型 |
|---|---|---|---|
| CSB-PA008651GA01HU | FGG Antibody | Human,Mouse,Rat | ELISA,WB |
| CSB-PA008651LA01HU | FGG Antibody | Human, Mouse | ELISA, WB, IHC, IF |
| CSB-PA008651LB01HU | FGG Antibody, HRP conjugated | Human | ELISA |
| CSB-PA008651LC01HU | FGG Antibody, FITC conjugated | Human | |
| CSB-PA008651LD01HU | FGG Antibody, Biotin conjugated | Human | ELISA |
FGG Proteins
FGG Proteins for Canis familiaris (Dog) (Canis lupus familiaris)
| 產(chǎn)品貨號 | 產(chǎn)品名稱 | 來源 |
|---|---|---|
| CSB-YP008651DO CSB-EP008651DO CSB-BP008651DO CSB-MP008651DO CSB-EP008651DO-B |
Recombinant Dog Fibrinogen gamma chain (FGG) | Yeast E.coli Baculovirus Mammalian cell In Vivo Biotinylation in E.coli |
FGG Proteins for Rattus norvegicus (Rat)
| 產(chǎn)品貨號 | 產(chǎn)品名稱 | 來源 |
|---|---|---|
| CSB-YP008651RA CSB-EP008651RA CSB-BP008651RA CSB-MP008651RA CSB-EP008651RA-B |
Recombinant Rat Fibrinogen gamma chain (Fgg) | Yeast E.coli Baculovirus Mammalian cell In Vivo Biotinylation in E.coli |
FGG Proteins for Homo sapiens (Human)
| 產(chǎn)品貨號 | 產(chǎn)品名稱 | 來源 |
|---|---|---|
| CSB-YP008651HU CSB-BP008651HU CSB-MP008651HU CSB-EP008651HU-B |
Recombinant Human Fibrinogen gamma chain (FGG) | Yeast Baculovirus Mammalian cell In Vivo Biotinylation in E.coli |
| CSB-EP008651HU | Recombinant Human Fibrinogen gamma chain (FGG) | E.coli |
FGG Proteins for Xenopus laevis (African clawed frog)
| 產(chǎn)品貨號 | 產(chǎn)品名稱 | 來源 |
|---|---|---|
| CSB-YP008651XBE CSB-EP008651XBE CSB-BP008651XBE CSB-MP008651XBE CSB-EP008651XBE-B |
Recombinant Xenopus laevis Fibrinogen gamma chain (fgg) | Yeast E.coli Baculovirus Mammalian cell In Vivo Biotinylation in E.coli |
FGG Proteins for Petromyzon marinus (Sea lamprey)
| 產(chǎn)品貨號 | 產(chǎn)品名稱 | 來源 |
|---|---|---|
| CSB-YP008651EUC CSB-EP008651EUC CSB-BP008651EUC CSB-MP008651EUC CSB-EP008651EUC-B |
Recombinant Petromyzon marinus Fibrinogen gamma chain (FGG) | Yeast E.coli Baculovirus Mammalian cell In Vivo Biotinylation in E.coli |
FGG Proteins for Mus musculus (Mouse)
| 產(chǎn)品貨號 | 產(chǎn)品名稱 | 來源 |
|---|---|---|
| CSB-YP008651MO CSB-EP008651MO CSB-BP008651MO CSB-MP008651MO CSB-EP008651MO-B |
Recombinant Mouse Fibrinogen gamma chain (Fgg) | Yeast E.coli Baculovirus Mammalian cell In Vivo Biotinylation in E.coli |
FGG ELISA Kit
FGG ELISA Kit for Homo sapiens (Human)
| 產(chǎn)品貨號 | 產(chǎn)品名稱 | 樣本類型 | 靈敏度 |
|---|---|---|---|
| CSB-E13319h | Human Fibrinogen Gamma Chain (FGG)ELISA Kit | serum, plasma, tissue homogenates | 31.25 ng/mL |











